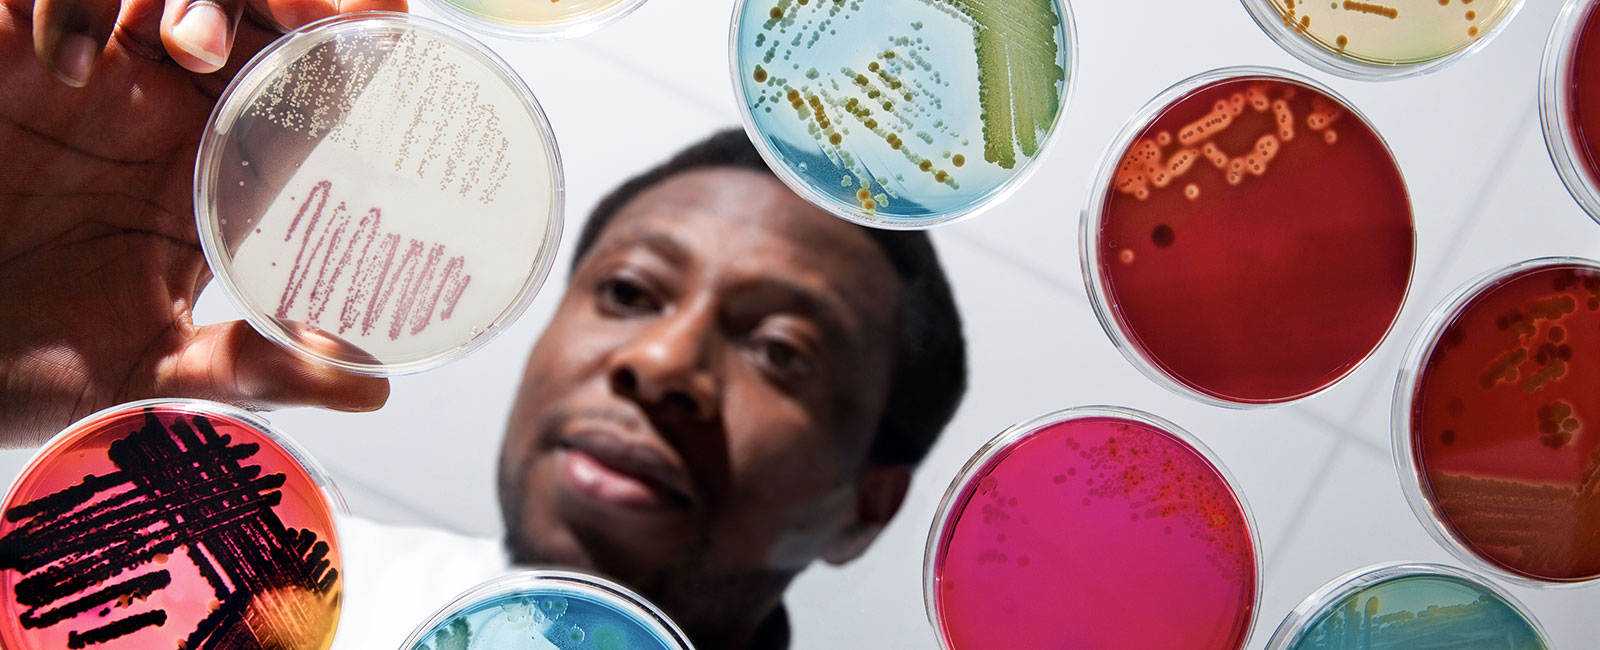

La iniciativa DNDi, Premio Fronteras del Conocimiento de Cooperación al Desarrollo
El Premio Fundación BBVA Fronteras del Conocimiento en la categoría de Cooperación al Desarrollo ha sido concedido en su quinta edición a la Iniciativa Medicamentos para Enfermedades Olvidadas (DNDi por sus siglas en inglés) por “desarrollar y distribuir junto a sus colaboradores tratamientos nuevos y accesibles para enfermedades ligadas a la pobreza, incluidas el Chagas, la enfermedad del sueño, la malaria o la leishmaniasis, que afectan a las poblaciones más vulnerables del mundo”, según el acta del jurado. Y añade que “DNDi representa un modelo institucional de buenas prácticas, que traslada la investigación científica a la cooperación al desarrollo mediante la gestión del conocimiento y la difusión de resultados para la poblaciones desfavorecidas que sufren las enfermedades olvidadas”.
26 febrero, 2013
Al conocer la noticia del premio, el director de la DNDi, Bernard Pécoul, ha manifestado que se siente feliz “por la institución, pero también por los enfermos olvidados, que son los que están en el centro de la iniciativa”. DNDi no sólo cubre el vacío en cuanto a investigación en enfermedades olvidadas y ligadas a la pobreza, sino que promueve la producción de los fármacos resultantes a costes asequibles y se asegura de su distribución entre quienes los necesitan.
“A pesar del progreso de la salud pública en el último siglo, todavía persisten diferencias significativas y muchas de las enfermedades que afectan a las poblaciones más pobres siguen olvidadas. La falta de incentivos para los mercados provoca que se dedique solo el 10 por ciento del gasto en investigación a enfermedades que representan el 90 por ciento del coste en la salud mundial. Controlar y eliminar esas enfermedades es un componente vital en la estrategia para aliviar la pobreza”, señala el acta.
Y ése es precisamente el objetivo de la organización ganadora, como explica su director, Bernard Pécoul: “Las enfermedades olvidadas afectan a mucha población, pero es gente que no tiene interés económico, no puede sostener un mercado, y por eso no hay inversión del sector privado. Son enfermedades que provocan la muerte o que gente joven que las padece no pueda trabajar. Es una carga para las familias, para los pueblos. El impacto económico es muy fuerte. Allí donde estas enfermedades tienen una alta prevalencia, el desarrollo económico se ve afectado muy negativamente”.
Se estima que más de mil millones de personas -una de cada seis en el mundo- padece alguna de las 17 enfermedades tropicales consideradas olvidadas por la OMS, y de ellas 500 millones son niños. Estas enfermedades causan medio millón de muertes al año. Si a estos datos se añaden las de otras patologías ligadas a la pobreza como la malaria, la población afectada llega a los 3.000 millones de personas.
La organización premiada sigue el modelo de “Colaboraciones para el Desarrollo de Productos” (PDP por sus siglas en inglés), con una eficacia demostrada que destaca el acta de del jurado: “Ha trabajado con éxito con el mundo académico, la industria, las ONG y los gobiernos de todo el mundo, para desarrollar e implementar seis nuevos tratamientos contra la malaria, Chagas, enfermedad del sueño y leishmaniasis. Estas enfermedades afectan a 3.000 millones de personas. Algunos de sus nuevos fármacos se han aplicado en más de 30 países de África, Asia y Latinoamérica, y por poner un ejemplo, se han distribuido más de 150 millones de dosis de sus tratamientos contra la malaria”.
Medicamentos para Enfermedades Olvidadas es una organización sin ánimo de lucro que nació en 2003 por la iniciativa conjunta de siete instituciones públicas y privadas: Médicos sin Fronteras, Consejo Indio de Investigación Médica, Instituto de Investigación Médica de Kenya, Ministerio de Salud de Malasia, Instituto Pasteur (Francia), la Fundación Oswaldo Cruz (Fiocruz) de Brasil, y el Programa Especial para la Investigación y Entrenamiento en Enfermedades Olvidadas de la Organización Mundial de la Salud.
Con un equipo de unas 120 personas repartidas en sus sedes de Suiza, Brasil, Congo, Kenia, India, Malasia, Estados Unidos y Japón, coordina una red de colaboradores que integra un total de 600 personas que trabajan en contacto con las instituciones públicas y privadas que se implican en cada proyecto concreto.
El objetivo de DNDi es descubrir y desarrollar nuevos tratamientos para las “enfermedades olvidadas” y para otras ligadas a la pobreza, asegurándose además de que sean accesibles de forma equitativa para la población de los países más desfavorecidos. Dadas las condiciones de los destinatarios, el tratamiento ideal debe tener las propiedades de ser administrado oralmente, ser seguro, eficaz, de bajo costo y corta duración. “El diagnóstico debe ser sencillo y el hecho de que sea oral y de corta duración es para evitar que tengan que desplazarse horas o incluso días para recibir un tratamiento hospitalario”, afirma Pécoul.
La estrategia de DNDi consiste en detectar la necesidad de un tratamiento e implicar tanto a instituciones públicas como privadas, incluidos laboratorios farmacéuticos, para desarrollarlo, producirlo y distribuirlo. Pécoul habla de la relación con la industria farmacéutica: “Hemos conseguido firmar contratos con muchos laboratorios incluso en niveles muy tempranos del desarrollo de fármacos, y puedo decir que hemos tenido bastante éxito en estas relaciones. Ellos saben que no van a hacer negocio, pero son proyectos que encuentran apoyo dentro de los propios equipos de la empresas y además se dan cuenta de que en estos países está el mercado del futuro”.
Desde su creación, DNDi ha logrado seis nuevos tratamientos adaptando otros anteriormente existentes a las necesidades y condiciones de los países afectados. En concreto son dos tratamientos contra la malaria –ASAQ, en colaboración con Sanofi, fabricado en África y distribuido en 32 países; y ASMQ, basado en una tecnología transferida desde Brasil a la India-; uno contra la enfermedad del sueño –NECT, que ha sustituido a tratamientos anteriores más tóxicos y caros-; otros dos contra la leishmaniasis –que acortan la duración del tratamiento y se aplican en África del Este y Asia- y un sexto contra la enfermedad de Chagas, con una nueva dosificación de uso pediátrico, desarrollada por un laboratorio público brasileño.
De sus éxitos, Pécoul destaca el tratamiento para la enfermedad del sueño: “Fue un gran cambio. Yo he trabajado más de 20 años con MSF y era difícil entrar en un hospital sabiendo que al usar medicinas derivadas del arsénico, un 5% de los pacientes iban a morir por la toxicidad del tratamiento. Pero no teníamos otra solución porque la enfermedad del sueño mataba al 100 por cien”.
El jurado ha destacado que labor de DNDi abarca el diseño, la evaluación, el registro, la producción y la implementación de los fármacos. Y todo ello bajo los más estrictos estándares de calidad y seguridad e intentando siempre llevar la investigación y producción a los propios países afectados y trabajar con las instituciones y organizaciones tanto públicas como privadas que trabajan sobre el terreno para implementar los resultados.
Pécoul ha señalado un cambio en la dirección de la investigación: “Antes procedía del norte y se dirigía a ayudar al sur. En nuestro modelo hay ese tipo de colaboración, pero también la interacción entre países del sur que se ayudan mutuamente y en el futuro podemos llegar a un nuevo enfoque en el que, por ejemplo, la solución para el problema de Chagas que tienen en España llegue desde Brasil o Argentina”.
Actualmente el DNDi está promoviendo investigación para tratar otras dos enfermedades: la filariasis y el VIH pediátrico. Tiene en marcha un total de 30 proyectos en diferentes etapas del proceso y 11 de ellos son candidatos a generar nuevos fármacos. “Estamos trabajando en un tratamiento oral de una semana para la enfermedad del sueño, pero parece que puede ser eficaz también para leishmaniasis y Chagas. Si hay éxito, podríamos tener un tratamiento único para tres enfermedades ligadas a la pobreza con un precio mucho más bajo que los que tenemos ahora mismo”, ha comentado.
La financiación de DNDi procede a partes iguales de la iniciativa pública -gobiernos e instituciones- y de la privada –fundaciones, ONG y otras entidades-. “La situación actual de Europa es preocupante. Por eso intentamos diversificar, para que cuando un gobierno no pueda ayudarnos, podamos seguir con otras fuentes de apoyo y, así, mantener nuestra actividad”.
Jurado internacional
El jurado de esta categoría está presidido por Pedro Alonso, director del Instituto de Salud Global de Barcelona (ISGlobal) CRESIB del Hospital Clinic-Universitat de Barcelona y cuenta como secretario con José García Montalvo, vicerrector de Política Científica de la Universitat Pompeu Fabra de Barcelona.
El resto de los miembros son Maricela Daniel, representante de la Delegación en España del Alto Comisionado de las Naciones Unidas para los Refugiados (ACNUR), Vicente Larraga, profesor de investigación del Centro de Investigaciones Biológicas del Consejo Superior de Investigaciones Científicas (CSIC) y Francisco Pérez, catedrático de Análisis Económico de la Universitat de València y director de Investigación del Instituto Valenciano de Investigaciones Económicas (IVIE).